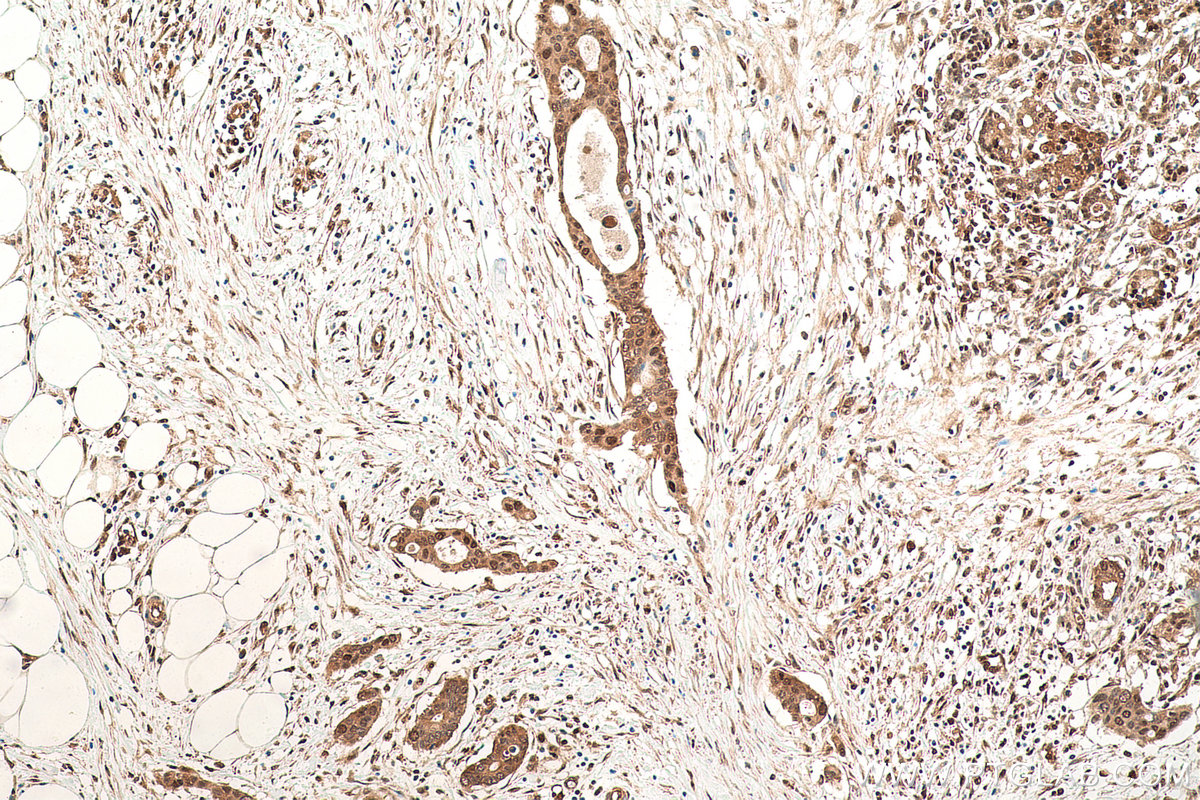

验证数据展示
经过测试的应用
| Positive WB detected in | RAW 264.7 cells, WT and VCP KO U2OS cells, SH-SY5Y cells, HeLa cells |
| Positive IHC detected in | human colon cancer tissue, human lung cancer tissue, human ovary tumor tissue, human pancreas cancer tissue, human stomach cancer tissue, mouse brain tissue, mouse colon tissue Note: suggested antigen retrieval with TE buffer pH 9.0; (*) Alternatively, antigen retrieval may be performed with citrate buffer pH 6.0 |
| Positive IF/ICC detected in | HeLa cells, SH-SY5Y cells |
| Positive FC (Intra) detected in | HL-60 cells |
推荐稀释比
| 应用 | 推荐稀释比 |
|---|---|
| Western Blot (WB) | WB : 1:500-1:2000 |
| Immunohistochemistry (IHC) | IHC : 1:500-1:2000 |
| Immunofluorescence (IF)/ICC | IF/ICC : 1:400-1:1600 |
| Flow Cytometry (FC) (INTRA) | FC (INTRA) : 0.40 ug per 10^6 cells in a 100 µl suspension |
| It is recommended that this reagent should be titrated in each testing system to obtain optimal results. | |
| Sample-dependent, Check data in validation data gallery. | |
产品信息
60316-1-Ig targets VCP in WB, IHC, IF/ICC, FC (Intra), ChIP, ELISA applications and shows reactivity with human, mouse samples.
| 经测试应用 | WB, IHC, IF/ICC, FC (Intra), ELISA Application Description |
| 文献引用应用 | WB, IF, ChIP |
| 经测试反应性 | human, mouse |
| 文献引用反应性 | human |
| 免疫原 |
CatNo: Ag1002 Product name: Recombinant human VCP protein Source: e coli.-derived, PGEX-4T Tag: GST Domain: 345-644 aa of BC007562 Sequence: GMTPSKGVLFYGPPGCGKTLLAKAIANECQANFISIKGPELLTMWFGESEANVREIFDKARQAAPCVLFFDELDSIAKARGGNIGDGGGAADRVINQILTEMDGMSTKKNVFIIGATNRPDIIDPAILRPGRLDQLIYIPLPDEKSRVAILKANLRKSPVAKDVDLEFLAKMTNGFSGADLTEICQRACKLAIRESIESEIRRERERQTNPSAMEVEEDDPVPEIRRDHFEEAMRFARRSVSDNDIRKYEMFAQTLQQSRGFGSFRFPSGNQGGAGPSQGSGGGTGGSVYTEDNDDDLYG 种属同源性预测 |
| 宿主/亚型 | Mouse / IgG1 |
| 抗体类别 | Monoclonal |
| 产品类型 | Antibody |
| 全称 | valosin-containing protein |
| 别名 | 15S Mg(2+) ATPase p97 subunit, 15S Mg(2+)-ATPase p97 subunit, 2A4B10, EC:3.6.4.6, HEL-220 |
| 计算分子量 | 89 kDa |
| 观测分子量 | 89 kDa |
| GenBank蛋白编号 | BC007562 |
| 基因名称 | VCP |
| Gene ID (NCBI) | 7415 |
| RRID | AB_2881427 |
| 偶联类型 | Unconjugated |
| 形式 | Liquid |
| 纯化方式 | Protein G purification |
| UNIPROT ID | P55072 |
| 储存缓冲液 | PBS with 0.02% sodium azide and 50% glycerol, pH 7.3. |
| 储存条件 | Store at -20°C. Stable for one year after shipment. Aliquoting is unnecessary for -20oC storage. |
背景介绍
VCP(Valosin-containing protein), also known as TER ATPase and 15S Mg2+-ATPase p97 subunit, belongs to the AAA ATPase family. VCP was first identified as a result of attempts to clone a putative peptide hormone called valosin. It was found that the cloned cDNA encoded a ubiquitously expressed 90 kDa cytosolic protein, termed VCP, which showed none of the characteristics of a peptide hormone precursor(PMID:1382975). Defects in VCP are the cause of inclusion body myopathy with early-onset Paget disease and frontotemporal dementia (IBMPFD) and amyotrophic lateral sclerosis type 14 with or without frontotemporal dementia (ALS14). VCP has a calculated molecular weight of 89 kDa and an apparent molecular weight of 90-100 kDa (PMID: 15732117, 1382975).
实验方案
| Product Specific Protocols | |
|---|---|
| FC protocol for VCP antibody 60316-1-Ig | Download protocol |
| IF protocol for VCP antibody 60316-1-Ig | Download protocol |
| IHC protocol for VCP antibody 60316-1-Ig | Download protocol |
| WB protocol for VCP antibody 60316-1-Ig | Download protocol |
| Standard Protocols | |
|---|---|
| Click here to view our Standard Protocols |
发表文章
| Species | Application | Title |
|---|---|---|
Brain Interactome screening of C9orf72 dipeptide repeats reveals VCP sequestration and functional impairment by polyGA.
| ||
Acta Pharmacol Sin Gossypol, a novel modulator of VCP, induces autophagic degradation of mutant huntingtin by promoting the formation of VCP/p97-LC3-mHTT complex. | ||
Biochim Biophys Acta Gene Regul Mech GLI1, a novel target of the ER stress regulator p97/VCP, promotes ATF6f-mediated activation of XBP1 | ||
Research (Wash D C) SERBP1 Promotes Stress Granule Clearance by Regulating 26S Proteasome Activity and G3BP1 Ubiquitination and Protects Male Germ Cells from Thermostimuli Damage | ||
Sci Adv p37 regulates VCP/p97 shuttling and functions in the nucleus and cytosol
|